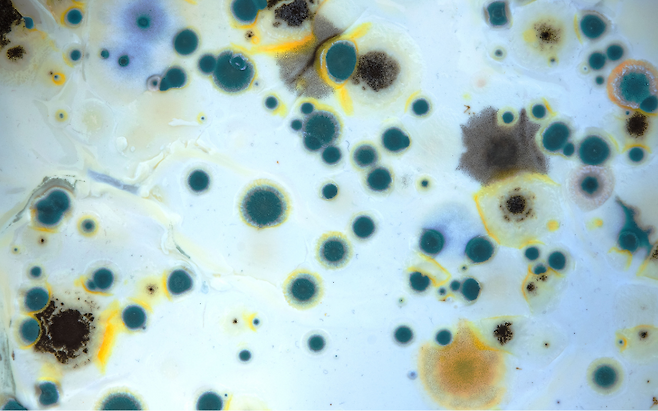

집에서 물을 간편하게 끓일 때 자주 쓰는 전기포트. 하지만 관리 방법에 따라서는 끓인 물에 세균이나 이물질이 그대로 섞여 나올 수 있다는 사실, 알고 계신가요?
전기포트 내부는 고온을 견디는 구조라 위생 관리가 소홀해지기 쉽지만, 제대로 관리하지 않으면 건강에 악영향을 줄 수 있습니다.
물때와 석회질이 세균의 온상이 됩니다

전기포트를 오래 사용하다 보면 내부 벽면에 흰색 가루나 누런 물때가 끼는 경우가 많습니다.
이것은 칼슘, 마그네슘 같은 미네랄이 굳어 생긴 ‘석회질’인데, 표면이 거칠어 세균이 붙어 자라기 쉬운 환경을 만듭니다. 겉으로는 깨끗해 보여도 미세한 틈새에서 세균 번식이 이뤄질 수 있습니다.
끓인다고 다 해결되지 않습니다

많은 분들이 “어차피 물을 끓이면 세균이 죽으니까 괜찮지 않을까?”라고 생각합니다. 하지만 포트 안쪽에 이미 자리 잡은 곰팡이균이나 세균이 내놓는 독성 물질은 단순히 끓이는 과정만으로 완전히 제거되지 않을 수 있습니다.
실제로 물맛이 탁해지거나 특유의 쓴맛, 비린내가 나는 경우가 여기에 해당합니다.
관리법: 식초나 베이킹소다로 정기적으로 청소하세요

전기포트를 안전하게 쓰려면 최소 2주에 한 번은 청소하는 것이 좋습니다.
물을 절반가량 채운 뒤 식초 한두 스푼이나 베이킹소다를 넣고 끓인 다음, 30분 정도 두었다가 깨끗한 물로 여러 번 헹궈내면 세균과 물때를 효과적으로 제거할 수 있습니다. 사용 후에는 뚜껑을 열어 습기가 마르도록 두는 것도 중요합니다.

전기포트는 하루에도 몇 번씩 사용하는 생활 필수품입니다. 그러나 내부 상태를 확인하지 않고 계속 쓰면, 끓인 물 속에 세균이 그대로 섞여 건강을 위협할 수 있습니다.
청소 주기만 지켜도 물맛은 훨씬 깔끔해지고 위생까지 챙길 수 있으니 오늘 꼭 한번 점검해보시기 바랍니다.
Copyright © 뇌생각